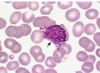
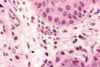
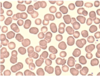
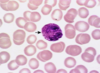
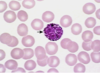
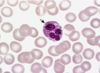
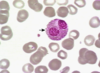
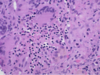
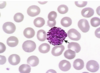
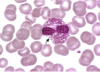
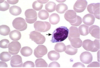
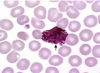
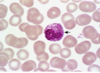
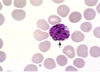
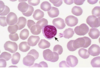
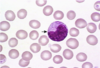
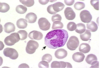
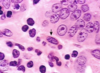
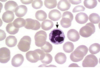
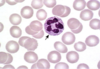
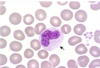
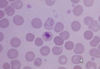
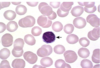
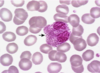
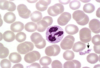
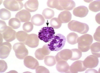
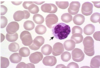
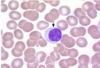
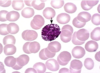
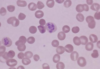
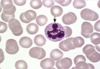
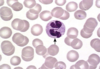
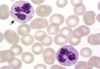
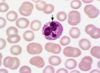
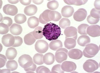
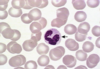
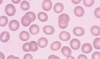
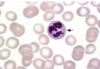
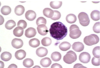
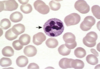
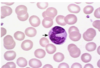
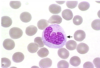

Slide Exam 1 Flashcards
(386 cards)
1
Q

A
Mixed (Seromucous) Gland
2
Q

A
Type 2 Collagen
3
Q
What collagen forms this structure?

A
Type 4 Collagen
4
Q

A
Stratified Squamous (keratinized)
5
Q

A
Mast Cell
(basophil that has entered tissue)
6
Q

A
Eosinophil
7
Q

A
Pseudostratified Columnar Epithelia
8
Q

A
Apoptosis
9
Q

A
Prophase
10
Q

A
Myelinated Neuron
11
Q

A
Microvilli
12
Q

A
Skeletal Muscle
13
Q

A
Smooth Muscle
14
Q

A
Pseudostratified Columnar Epithelia
15
Q

A
Fibroblast
16
Q

A
Mitochondria
17
Q

A
Anaphase
18
Q

A
Mixed (Seromucous) Gland
19
Q

A
Serous Gland
20
Q

A
Basophil
21
Q

A
Neuron (soma and axon)
22
Q

A
- Stratified epithelium, modified for distensibility
- Appears to be about 4-5 cell layers thick when relaxed, 2-3 when stretched
- Varies from squamous to cuboidal
- Distinct feature: surface edge is not flat
23
Q

A
Eosinophil
24
Q

A
Endoplasmic Reticulum
25

Melanin Intracytoplasmic Pigment
26

Simple Squamous Epithelium
27

Prophase
28

Endocardium and Myocardium
29

- Stratified epithelium, modified for distensibility
- Appears to be about 4-5 cell layers thick when relaxed, 2-3 when stretched
- Varies from squamous to cuboidal
- Distinct feature: surface edge is not flat
30

Microvilli
31
Fringe on top?

Cilia
32

Purkinje Fibers
33

Stratified Squamous (non-keratinized)
34

Anaphase
35

Metaphase
36
Baosphil
37
Review

38

Melanin Intracytoplasmic Pigment
39
Loose (Areolar) Connective Tissue
40

Skeletal Muscle Cells
41

Prophase
42

Irregular Dense Connective Tissue
43

Smooth Muscle
44
Erythrocytes
45

Ependymal Cells
(lines ventricles and central canal of spinal cord, often have cilia)
46

Melanin Intracytoplasmic Pigment
47

Stratified Cuboidal Epithelium
48

Regular Dense Connective Tissue
49

Simple Squamous Epithelium
50

White Adipose Tissue
51

Goblet Cells
52
Eosinophil
53

Choroid Plexus
| (cuboidal epithelium that secretes CSF)
54
Basophil
55

Microvilli
56

Cerebrum (cortex)
(peripheral gray matter, cental white matter)
57

Simple Squamous Epithelium
58

Ependymal Cells
(lines ventricles and central canal of spinal cord, often have cilia)
59

Satellite Cell
60

Eosinophil
61
Eosinophil
62

Telophase
63
Eosinophil
64

Purkinje Fibers
(larger than surrounding cardiac muscle cells, joined by gap junctions)
65

Pseudostratified Columnar Epithelia
66

Epicardium and Myocardium
67

Elastic Fiber
68

Telophase
69

Reticulocytes
70

Prophase
71

Irregular Dense Connective Tissue
72
Apoptosis
73

Eosinophil
74
Basophil
75
Eosinophil
76

Serous Gland
77

Regular Dense Connective Tissue
78
What collagen forms this structure?

Type 4 Collagen
79
Lymphocyte
80

Cerebellum
81

Irregular Dense Connective Tissue
82

Smooth Muscle
83

Loose (Areolar) Connective Tissue
84

Neuromuscular Junctions
85

Loose (Areolar) Connective Tissue
86

Cardiac Valve
87

Spinal Cord
| (likely gray matter)
88

Pseudostratified Columnar Epithelia
89

Elastic Fibers
90

Purkinje Fibers
91

Elastic Fibers
92

Endocardium and Myocardium
93

Spina cord
| (likely gray matter)
94

Mucous Gland
95

Smooth Muscle
96
Fringe on top

Cilia
97

Pseudostratified Columnar Epithelia
98

Serous Gland
99

Lampbrush Chromosomes (euchromatin)
100

Type 3 Collagen (silver stained reticulin fibers)
101

Mucous Gland
102

Lampbrush Chromosomes (euchromatin)
103

Spinal Cord
104

Neuromuscular Junctions
105

Myoepithelial Cells
(muscle epithelial hybrid used to squeeze product into acini)
106

Barr Body
107

Elastic Fiber
108

Stratified Cuboidal Epithelium
109

Irregular Dense Connective Tissue
110
Cardiac Tissue Organization Review

111

Axons surrounded by Schwann Cells
112

Metaphase
113

SA Node
114

Prophase
115

Howell-Jolly Body in Erythrocytes
116

Ganglia (look like fried egg)
117
Cardiac Tissue Organization Review

118

Cardiac Valve
119
Basophil
120

Elastic Fibers
121

Metaphase
122
What layers of the meninges are these?

Arachnoid and pia (on surface of brain)
123
Skeletal Muscle Organization Review

124

Type 2 Collagen
125

Loose (Areolar) Connective Tissue
126
Eosinophil
127

Metaphase
128

Elastic Fibers
129

Golgi Apparatus
130

Apoptosis
131
Basophil
132

Goblet Cells
133

- Stratified epithelium, modified for distensibility
- Appears to be about 4-5 cell layers thick when relaxed, 2-3 when stretched
- Varies from squamous to cuboidal
- Distinct feature: surface edge is not flat
134

Goblet Cells
135

Loose (Areolar) Connective Tissue
136

Metaphase
137

Type 1 Collagen
138

Microvilli
139

Stratified Squamous (non-keratinized)
140

Loose (Areolar) Connective Tissue
141

Mixed (Seromucous) Gland
142

Regular Dense Connective Tissue
143

Dura, Arachnoid, Pia
144

Golgi Apparatus
145

Prophase
146

Neuromuscular/Neurotendinous Spindles
147

Cerebellum
148

Basement Membrane
149

Choroid Plexus
150

Intercalated Discs
151

Stratified Columnar Epithelium
152

Skeletal Muscle
153

Telophase
154

Mast Cell
| (basophil that has entered tissue)
155

Epicardium and Myocardium
156

Choroid Plexus
157

Loose (Areolar) Connective Tissue
158
Fringe on top?

Cili
159

Elastic Fibers
160

Astrocytes
161

Smooth Muscle
162

Fibroblast
163

Rough Endoplasmic Reticulum
164

Neutrophil
165
Lymphocyte
166

Mast Cell
| (basophil that has entered tissue)
167

- Stratified epithelium, modified for distensibility
- Appears to be about 4-5 cell layers thick when relaxed, 2-3 when stretched
- Varies from squamous to cuboidal
- Distinct feature: surface edge is not flat
168
Monocyte
169

- Stratified epithelium, modified for distensibility
- Appears to be about 4-5 cell layers thick when relaxed, 2-3 when stretched
- Varies from squamous to cuboidal
- Distinct feature: surface edge is not flat
170

Anaphase
171

Cell Membrane
172

Golgi Apparatus
173

Simple Columnar Epithelial Tissue
174

Smooth Muscle
175
Monocyte
176
Mast Cell
| (basophil that has entered tissue)
177

Mixed (Seromucous) Gland
178

Cerebellum
| (layers separated by purkinje cells)
179

Myelopoiesis
180
Neutrophil
181

Smooth Muscle
182

Stratified Columnar Epithelium
183

Pseudostratified Columnar Epithelia
184

Neuromuscular/Neurotendinous Spindles
185

Purkinje Fibers
186

Smooth Muscle
187

Junctional Complex (terminal bar)
188

Irregular Dense Connective Tissue
189

Cardiac Valve
190

Skeletal Muscle
191

Purkinje Fibers
192

Cardiac Muscle (Myocardium)
193

Stratified Squamous (keratinized)
194

Stratified Squamous (keratinized)
195

Loose (Areolar) Connective Tissue
196

Epicardium and Myocardium
197

- Stratified epithelium, modified for distensibility
- Appears to be about 4-5 cell layers thick when relaxed, 2-3 when stretched
- Varies from squamous to cuboidal
- Distinct feature: surface edge is not flat
198

Smooth Endoplasmic Reticulum
199

Ependymal Cells
(lines ventricles and central canal of spinal cord, often have cilia)
200

Hemidesmosomes
(hemidesmosomes are located along basement membrane to anchor cells)
201

Smoother Muscle
202

Nuclear Pore
203

Microvilli
204
Neutrophil
205

Brown Adipose Tissue
206

Purkinje Fibers
207

Ependymal Cells
(lines ventricles and central canal of spinal cord, often have cilia)
208

Goblet Cells
209

Intercalated Discs
210
Monocyte
211
Reticulocytes
212

Fibroblast
213

Cardiac Valve
214

Cerebellum
215

Stratified Squamous (non-keratinized)
216

Prophase
217

Neuron (soma and axon)
218

Melanin Intracytoplasmic Pigment
219

Anaphase
220

White Adipose Tissue
221

Type 3 Collagen (black reticulin fibers stain with silver)
222

Serous Gland
223

Stratified Squamous (keratinized)
224

Mitochondria
225

Neuron (soma and axon)
226

Elastic Fibers
227

Endocardium and Myocardium
228

Cardiac Valve
229

Microvilli
230

Nuclear Pore
231

Mixed (Seromucous) Gland
232
Lymphocyte
233

Cardiac Valve
234

Endocardium and Myocardium
235

Cardiac Valve
236

Simple Squamous Epithelium
237
Eosinophil
238

- Stratified epithelium, modified for distensibility
- Appears to be about 4-5 cell layers thick when relaxed, 2-3 when stretched
- Varies from squamous to cuboidal
- Distinct feature: surface edge is not flat
239

Brown Adipose Tissue
240

Stratified Cuboidal Epithelium
241

Barr Body
242

Simple Cuboidal Epithelium
243

Skeletal Muscle
244

Simple Columnar Epithelial Tissue
245

Mucous Gland
246
Platelets
247
Basophil
248

Loose (Areolar) Connective Tissue
249

Mast Cell
| (basophil that has entered tissue)
250

Prophase
251

Type 1 Collagen
252

Prophase
253
Monocyte
254

Neutrophil
255

Elastic Fibers
256

Cardiac Valve
257

Hemidesmosomes
(hemidesmosomes are located along basement membrane to anchor cells)
258

Endoplasmic Reticulum
259

Lipofuscin Intracytoplasmic Pigment
260

Telophase
261

Spinal Cord
262

Cardiac Muscle) Myocardium
263

Satellite Cells around neurons
264

Mucous Gland
265

Regular Dense Connective Tissue
266

Cerebellum
267
Lymphocyte
268
Basophil
269

Endocardium and Myocardium
270

Purkinje Fibers
271

Cerebellum
272

Brown Adipose Tissue
273

Ependymal Cells
(lines ventricles and central canal of spinal cord, often have cilia)
274

Cerebellum
275
Reticuloctyes
276

Fibroblasts
277

Stratified Squamous (non-keratinized)
278

Cardiac Valve
279

Eosinophil
280
Peripheral Nervous Tissue Organization

281

Smooth Muscle
282

Basement Membrane
283

Prophase
284

Cardiac Valve
285

Mixed (Seromucous) Gland
286

Stratified Squamous (non-keratinized)
287

Intercalated Discs
288

Desmosomes
289
Neutrophil
290
Neutrophil
291

Cardiac Muscle
292

Ganglia (look like fried egg)
293

Irregular Dense Connective Tissue
294

Smooth Muscle
295

Purkinje Fibers
296

Prophase
297

Prophase
298

Epicardium and Myocardium
299

Goblet Cells
300

Central canal of spinal cord, lined with ependymal cells and filled with CSF
301

Cell Membrane
302
Dark stained structure: ?
Lighter stained circular structures: ?

Darker: Schwann Cell Body
Lighter: axons surrounded by schwann cell cytoplasm
303

Astrocytes
304

- Stratified epithelium, modified for distensibility
- Appears to be about 4-5 cell layers thick when relaxed, 2-3 when stretched
- Varies from squamous to cuboidal
- Distinct feature: surface edge is not flat
305
Neutrophils
306

Epicardium and Myocardium
307
Eosinophil
308

Telophase
309

Simple Squamous Epithelium
310

Junctional Complex (terminal bar)
311

Endocardium and Myocardium
312

Lampbrush Chromosomes (euchromatin)
313

Ependymal Cells
(lines ventricles and central canal of spinal cord, often have cilia)
314

Metaphase
315
Basophils
316

Loose (Areolar) Connective Tissue
317

Stratified Cuboidal Epithelium
318

Simple Squamous Epithelium
319

Simple Cuboidal Epithelium
320

Type 1 Collagen
321

Smooth Endoplasmic Reticulum
322

Junctional Complex (terminal bar)
323

Neutrophils
324

Type 2 Collagen
325

Lymphocyte
326

Neutrophil
327

Spinal Cord
(central canal lined with ependymal cells)
328

Endocardium and Myocardium
329

Simple Squamous Epithelium
330

Simple Cuboidal Epithelium
331

Intercalated Discs
332

Telophase
333

Ependymal Cells
(lines ventricles and central canal of spinal cord, often have cilia)
334

Fibroblast
335
Neutrophil
336

Simple Squamous Epithelium
337

Stratified Squamous (non-keratinized)
338
Erythrocytes
339

Anaphase
340

Basement Membrane
341

Lipofuscin Intracytoplasmic Pigment
342
Neutrophil
343

Smooth Muscle
344

Simple Squamous Epithelium
345

Smooth Muscle
346

Myoepithelial Cells
(muscle epithelial hybrid used to squeeze product into acini)
347

Simple Cuboidal Epithelium
348

Elastic Fibers
349
What separates these two layers?

Cerebellum
| (layer of Purkinje Cells)
350

Regular Dense Connective Tissue
351

Regular Dense Connective Tissue
352

Monocyte
| (remember lavender cytoplasm)
353

Myelinated Neuron
354

Hemidesmosomes
(hemidesmosomes are located along basement membrane to anchor cells)
355

Metaphase
356

Pseudostratified Columnar Epithelia
357

Cell Membrane
358

Elastic Fibers
359

Ependymal Cells
(lines ventricles and central canal of spinal cord, often have cilia)
360
Lymphocyte
361
Neutrophil
362

Astrocytes
363

Mast Cell
| (basophil that has entered tissue)
364

Cerebellum
365

Epicardium and Myocardium
366

Simple Columnar Epithelial Tissue
367

Apoptosis
368

White Adipose Tissue
369

Loose (Areolar) Connective Tissue
370

Cerebrum (cortex)
(peripheral gray matter, cental white matter)
371

Anaphase
372

Lipofuscin Intracytoplasmic Pigment
373

Desmosomes
374

Spinal Cord
375
Monocyte
376

Mast Cell
| (basophil that has entered tissue)
377

Simple Columnar Epithelial Tissue
378

Ribosomes
379

Type 2 Collagen
380
Monocyte
381

Stratified Cuboidal Epithelium
382

Loose (Areolar) Connective Tissue
383

Desmosomes
384

- Stratified epithelium, modified for distensibility
- Appears to be about 4-5 cell layers thick when relaxed, 2-3 when stretched
- Varies from squamous to cuboidal
- Distinct feature: surface edge is not flat
385

MItochondria
386

Smooth Muscle